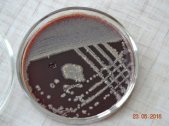

Клініко-діагностична лабораторія
Клініко-діагностична лабораторія (далі КДЛ) є структурним підрозділом лікарні, обслуговує пацієнтів відділень стаціонару, консультативно-діагностичної поліклініки, проводить централізовані цитологічні дослідження для закладів охорони здоров'я області. В структурі КДЛ входить 6 відділів: клініко-гематологічний, біохімічний, цитологічний, імуно-серологічний, бактеріологічний, ПЛР-діагностики. За вказаними напрямками працюють підготовлені лікарі, професіонали з вищою не медичною освітою та лаборанти.

Завідувачка КДЛ – Інна Миколаївна Іващенко, лікарка-вірусолог, вища кваліфікаційна категорія; лікарка-спеціаліст з клінічної лабораторної діагностики, гематології, патологічної анатомії.
.jpg)
Старший лаборант КДЛ – Валентина Андріївна Зикова, спеціаліст вищої кваліфікаційної категорії за фахом «Лабораторна справа. Клініка», має бакалаврський рівень освіти факультету «Технології медичної діагностики та лікування» Житомирського медичного інституту та здобувач магістерської освіти на факультеті «Громадське здоров’я» Житомирського медичного інституту. Стаж роботи 23 роки в клініко-діагностичній лабораторії обласної клінічної лікарні ім. О.Ф. Гербачевського.
Фахівці КДЛ залучені до навчального процесу підготовки спеціалістів з клінічної лабораторної діагностики та навчання лаборантів на циклах підвищення кваліфікації.
Щорічно в КДЛ виконується понад 1,6 млн досліджень, з них для пацієнтів обласної клінічної лікарні 74,7% та для інших закладів області 25,3%.
КДЛ оснащена сучасними автоматичними та напівавтоматичними аналізаторами, що дозволяє застосовувати сучасні методи лабораторної діагностики та забезпечувати якість виконаних досліджень.
В КДЛ функціонує система контролю якості, яка містить щоденний внутрішньолабораторний контроль за якістю лабораторних досліджень і регулярну щорічну участь в Національних та міжнародних Програмах з контролю якості лабораторних досліджень.
За напрямками роботи в КДЛ виконуються наступні дослідження:
клініко-гематологічні:
- мікроскопічні дослідження сечі, рідин з серозних порожнин, спинномозкової рідини, мокротиння, жовчі, випорожнень та іншого біологічного матеріалу;
- гематологічні дослідження периферичної крові виконуються на гематологічних аналізаторах;
- мікроскопічні дослідження мазків периферичної крові, пунктатів/аспіратів кісткового мозку з метою діагностики захворювань системи крові та виявлення метастазів;
- мікроскопічне дослідження урогенітальних мазків;
- дослідження крові на малярію;
- копрограма.
біохімічні :
- показники згортальної системи крові (визначення фібриногену, протромбінового часу, тромбінового часу, активованого часткового тромбопластинового часу, XII-а залежного фібринолізу, РФМК-тесту з орто-фенантроліном, визначення протромбінового часу з тромбопластином за міжнародним індексом чутливості (МНВ );
- активність ферментів (аланінамінотрансферази, аспартатамінотрансферази, лужної фосфатази, амілази, гамаглутамілтранспептидази, креатинфосфокінази, лактатдегідрогенази);
- білковий обмін (визначення загального білку, альбуміну, тимолової проби, С-реактивного білку);
- вуглеводний обмін (визначення глюкози, глікованого гемоглобіну на стандартизованій автоматизованій системі, проведення глікемічного профілю та тесту толерантності до глюкози);
- ліпідний обмін (визначення холестерину, тригліцеридів, ліпопротеїдів високої щільності (ЛПВЩ), ліпопротеїдів низької щільності (ЛПНЩ);
- водно-мінеральний обмін (визначення калію, натрію, хлоридів, фосфору, магнію, заліза, загального кальцію);
- пігментний обмін (визначення білірубіну);
- кількісне визначення Д-димеру (оцінка стану системи згортання крові).
імуно-серологічні:
- показники імунограми з визначенням факторів клітинного та гуморального імунітету з застосуванням CD-маркерів (кількість лімфоцитів, кількість В-лімфоцитів, кількість Т-лімфоцитів, Т-хелпери, Т-супресори), імуноглобуліни А, М, G та інше;
- визначенням імуноглобуліну Е;
- визначення маркерів гепатитів В і С;
- трепонемні та нетрепонемні тести на сифіліс;
- визначення титру антитіл до хламідій;
- визначення груп крові системи АВО та резус;
- визначення ревматоїдного фактору та антистрептолізину-О;
- кількісне визначення в крові прокальцитоніну (діагностика септичних станів;
- визначення імуноглобулінів класів M та G до коронавірусу;
- визначення антитіл до ВІЛ 1/2.
На автоматизованому обладнанні – імунохемілюмінесцентний аналізатор (ІХЛА) проводяться визначення наступних показників:
- тиреоїдна панель: тиреотропний гормон (тиреостимулюючий, тиреотропін, ТТГ, TSH), тироксин вільний (FT4), трийодтиронін вільний (FT3), антитіла до пероксидази щитоподібної залози (Anti-TPO), тиреоглобулін (Tg), антитіла до тиреоглобуліну (Anti-Tg);
- онкологічна панель: онкомаркер яйників (СА-125), онкомаркер підшлункової залози, жовчного міхура (СА 19-9), простат-специфічний антиген загальний (TPSA), простат-специфічний антиген вільний (FPSA), феритин;
- кардіомаркер: тропонін І.
- паратгормон
- виначення концентрації такролімусу/циклоспорину
- визначення імунологісних маркерів TORCH - інфекцій
- визначення маркерів вірусу Епштейна - Барр
бактеріологічні:
- визначення збудників інфекційних процесів в будь-якому біологічному матеріалі (сімейство кишкових бактерій (в томі числі умовнопатогенних (клебсієл, протеїв, ентеробактеру), стафілококи, стрептококи, дифтерія та інше);
- визначення кількості мікроорганізмів в біологічному матеріалі (мікробне число);
- визначення антибіотикочутливості мікроорганізмів до антибактеріальних препаратів;
- обстеження на дисбактеріоз кишківника.
цитологічні:
- цитологічні дослідження різних тканин та органів, отриманих під час діагностичних пункцій та операцій для визначення змін в клітинах, характерних для онкологічних, запальних та інших процесів;
- цитологічні скринінгові дослідження ексфоліативного клітинного матеріалу, отриманого при профілактичних гінекологічних, проктологічних, урологічних та ін. оглядах населення (секрети, виділення, зіскріби з поверхонь ерозій, виразок, ран, нориць, відбитки тканин/органів, промивні води, ексудати, транссудати та інші);
- дослідження ендоскопічного матеріалу отриманого при катетеризації бронхів, езофаго-, гастро-, дуодено-, лапаро-, ректо-, романо-, колоно-, цистоскопії та інших видів ендоскопічного обстеження при будь-якій локалізації патологічного процесу.
Впроваджено нові методи лабораторної діагностики та розширено перелік лабораторних досліджень.
Для визначення глікованого гемоглобіну впроваджено сучасну стандартизовану автоматизовану систему.
Показники згортаючої системи крові визначаються на сучасних приладах – коагулометрі, та автоматизованому коагулометрі, що дозволяє проводити моніторинг шляхів згортання крові та з метою контролю дії непрямих антикоагулянтів здійснюється стандартизоване визначення МНВ (INR).
Клінічний аналіз крові проводиться на гематологічних аналізаторах (3diff, 5diff), які визначають від 18 до 27 параметрів.
Напівкількісний аналізатор сечі дозволяє визначати 10 параметрів: глюкоза, білок, рН, відносну густину, білірубін, уробіліноген, кетонові тіла, нітрити, лейкоцити, еритроцити та додатково проводимо мікроскопію осаду.
В травні 2020 р. відкрито відділ ПЛР-діагностики, укомплектований сучасним обладнанням. Методика на отриманому обладнанні вирізняється високою чутливістю. Відділ успішно пройшов процедуру підтвердження лабораторних результатів у спеціалізованій лабораторії ДУ «Житомирський обласний Лабораторний центр МОЗ України», після якої КНП "Обласна лікарня" увійшла до переліку закладів Центру громадського здоров’я МОЗ України, які проводять ПЛР-дослідження на COVID-19.
З 14.07.2020 р. отримано доступ до електронної інтегрованої системи спостереження за захворюваннями, як заклад який проводить лабораторні дослідження методом ПЛР на визначення коронавірусу SARS-CoV-2 та ІФА на наявність антитіл до коронавірусу. Цей доступ дозволяє вносити результати ПЛР-негативних осіб, які виявили бажання припинити самоізоляцію /обсервацію та контроль місця перебування, в онлайн форму інтегровану із додатком «Дій вдома», щоб завершити термін самоізоляції або обсервації довчасно.
Також на підставі негативних результатів ПЛР-тесту на SARC-CoV-2 надаються медичні сертифікати для пред’явлення при перетині державного кордону.
З червня 2020 р. введенно в експлуатацію новий комплект обладнання для імуноферментного аналізу (ІФА) з метою виявлення імунологічних маркерів вірусу SARC-CoV-2 ( антитіла IgM, IgG). На підставі отриманих результатів по антитілах, можна з’ясувати чи перехворіла людина на COVID, чи спрацювала захисна система організму після контакту із вірусом.
Жителі області мають можливість в обласній клінічній лікарні отримати кваліфіковані консультації фахівців різних профілів та пройти одночасно стандартизоване лабораторне обстеження впродовж дня.
Клініко-діагностична лабораторія розташована за адресою: м. Житомир, вул. Червоного Хреста, 3, ІІІ-й поверх корпусу консультативно-діагностичної поліклініки.
КДЛ працює щоденно, ургентна зміна забезпечує виконання термінових лабораторних досліджень цілодобово та у вихідні дні.